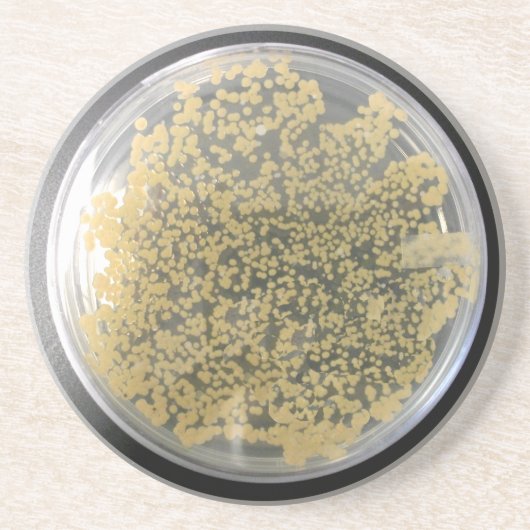
Dessous De Verre En Grès Plaque de culture bactérienne, colonies de bactéri (Devant)

13,30 €
par dessous de verre
Dessous De Verre En Grès Plaque de culture bactérienne, colonies de bactéri
Voir les détails du produitA propos de Dessous de verres
Vendu (e) par
À propos de ce design
Dessous De Verre En Grès Plaque de culture bactérienne, colonies de bactéri
Un dessous de verre que seul un microbiologiste pouvait aimer, admirer et mettre en place leurs délicieuses boissons. Nous ne sommes pas sûrs de ce que sont les colonies. Peut-être quelque chose que personne n'a jamais vu auparavant. Ou peut-être quelque chose à l'intérieur d'un tiroir de réfrigérateur. Cela ne vous donne-t-il pas simplement envie de prendre une boucle pour commencer à enquêter ? Ou peut-être pouvez-vous simplement le donner à quelqu'un qui travaille avec ces petits gars jour après jour, un endroit où ce dessous de verre se sentira aimé.
Traduction automatique
Avis des clients
Aucun commentaires sur ce produit pour le momentAvez-vous acheté ce produit ?
Tags
Autres infos
Identifiant du produit : 256104192455545418
Fabriqué le 30/11/2023 20:41
Évalué G
Articles vus récemment


